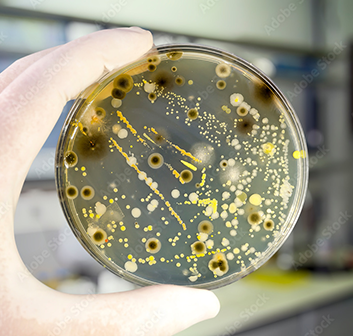

- To co-create an innovative antimicrobial nanocoatings platform with end-users.
- To demonstrate a superior and selective effectiveness against a broad spectrum of harmful pathogens, including representative bacteria, virus and fungi.
- To ensure a satisfactory durability and excellent adhesion of the coatings.
- To ensure a robust safety of the nanocoatings by implementing a Safe-by-Design approach.
- To validate the SUPREME nanocoatings for target applications.
- To ensure the environmental benefit of the nanocoatings using an eco-design approach and demonstrate the overall SUPREME sustainability.
- To demonstrate and showcase the feasibility to produce in a relevant innovative antimicrobial, antiviral and antifungal nanocoatings to key stakeholders.